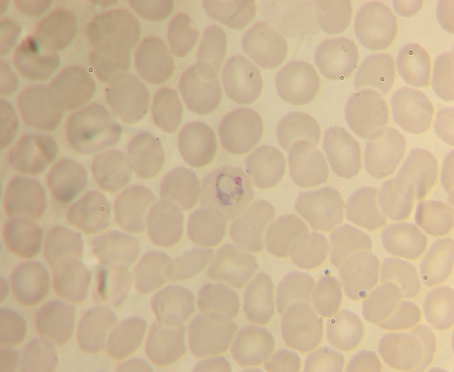
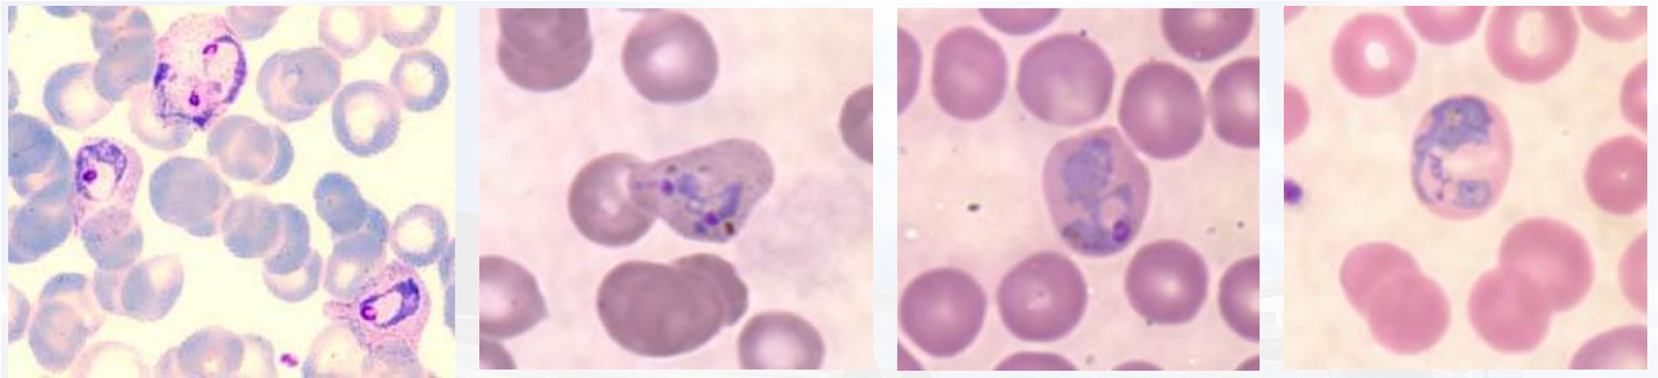
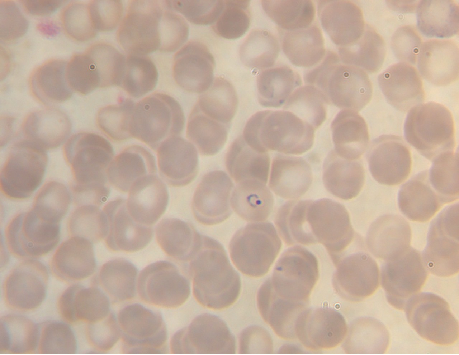
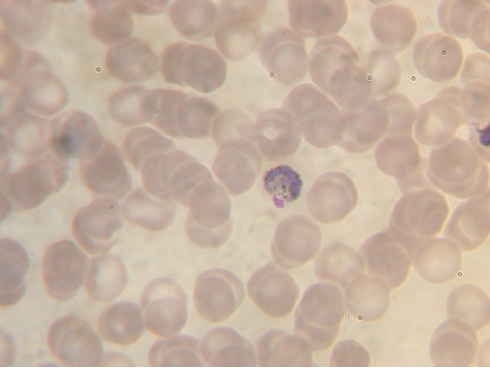
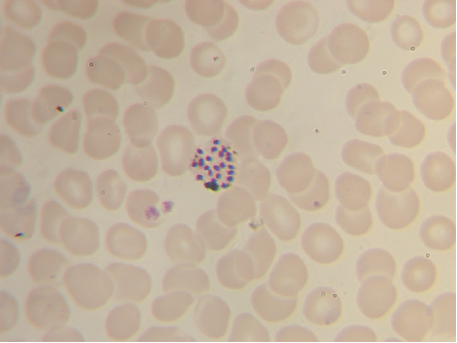

原虫
| Created | |
|---|---|
| Tags |
⚠️
💯往年标本考试题目 考过:阴道毛滴虫、蓝氏贾第鞭毛虫包囊、间日疟原虫!!!
蓝氏贾第鞭毛虫(包囊+滋养体)
疟原虫
三期六种形态
1.滋养体期:小、大滋养体
2.裂殖体期:未成熟、成熟裂殖体
3.配子体期:雌、雄配子体
💡
环状体
胞浆:环状,蓝色。
核:红色,
1个
大小约为红细胞直径的1/3
“红红的核,蓝蓝的浆”

💡
间日疟大滋养体
虫体增大。
胞浆:不规则,蓝色,出现伪足,有空泡。
有烟丝状疟色素,黄褐色。
核:红色,一个。
感染红细胞胀大,出现薛氏小点。

💡
间日疟未成熟裂殖体
虫体变圆,空泡消失。
红细胞胀大,褪色,有薛氏小点。
胞浆:蓝色,变多且尚未分裂。
核:开始分裂,2-12个。
疟色素烟丝状,集中成团。
💡
间日疟成熟裂殖体
红细胞胀大褪色
裂殖子12-24个,平均16个。
疟色素黄褐色,常集于一边。
💡
雌配子体核小致密,深红色,多偏于虫体一侧。疟色素均匀分布。
💡
雄配子体细胞质呈粉红色,核大疏松,染色较浅,多位于虫体中央。疟色素散在分布。
阴道毛滴虫
阴道毛滴虫仅有滋养体一个形态阶段,活体无色透明,有折光性,体态多变,活动力强。固定染色后虫体呈梨形,体长可达30μm,宽10~15μm。前端有一个泡状核,核上缘有5颗排列成环状的毛基体,由此发出5根鞭毛,分别为4根前鞭毛和1根后鞭毛。滋养体有轴柱1根,纤细透明,纵贯虫体,自后端伸出体外。虫体外侧前1/2处,有一波动膜,其外缘与向后延伸的后鞭毛相连。虫体借助鞭毛摆动前进,并借助波动膜的波动做旋转式运动。胞质内有深染的颗粒,为该虫特有的氢化酶体(hydrogenosome)
💡
阴道毛滴虫
梨形,前段有一个泡状核
阿米巴
结肠内阿米巴